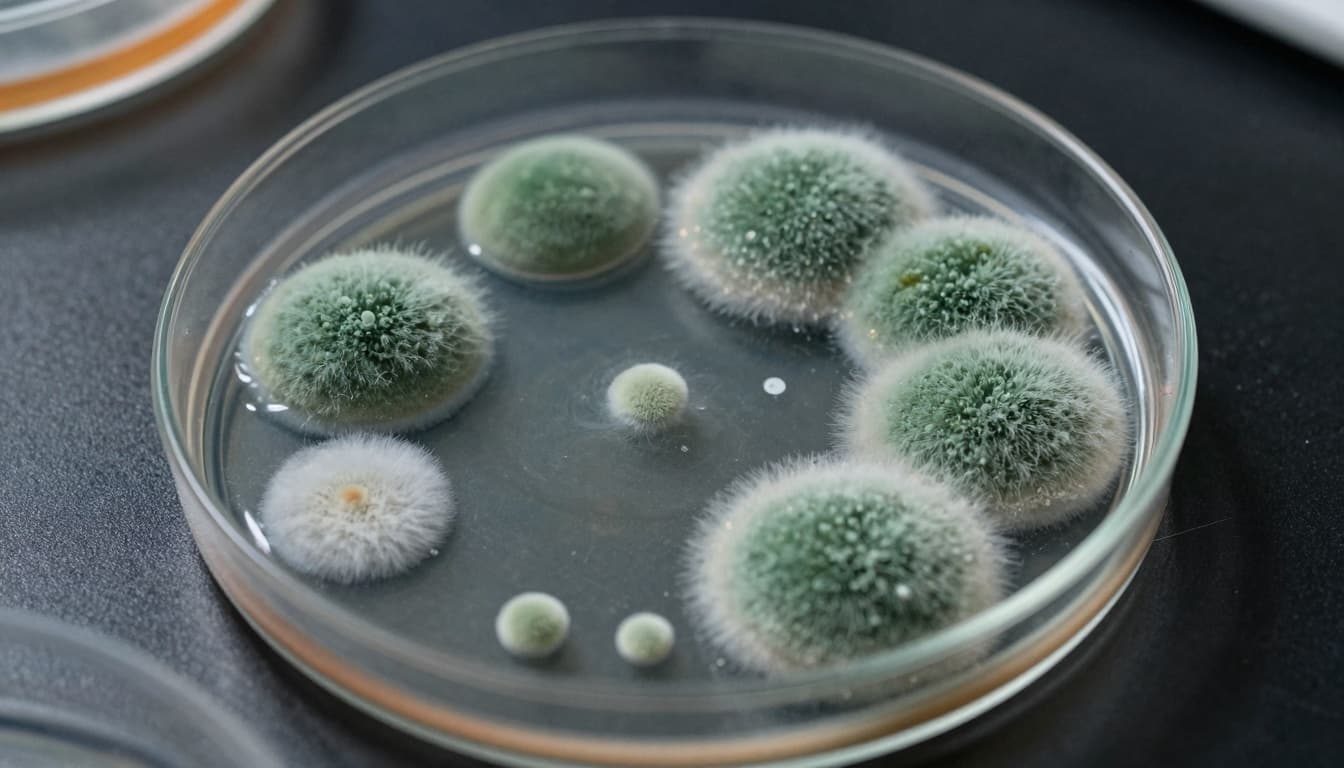
Macro shot of mold and microbial growth in a petri dish

A homeopathic nasal spray sold across the United States has been recalled because it may contain mold and harmful bacteria that could cause serious, and even life-threatening, infections in some people.
MediNatura New Mexico Inc. has issued a voluntary nationwide recall of its ReBoost Nasal Spray after testing showed the product was contaminated with yeast, mold, and bacteria. The U.S. Food and Drug Administration (FDA) shared details of the recall and advised customers to stop using the spray right away.
What Product Is Being Recalled?
The recall affects ReBoost Nasal Spray, a homeopathic product that contains echinacea and other herbal ingredients. According to the manufacturer, the spray is marketed to help with nasal congestion and cold or flu symptoms.
The recalled product is packaged in a white and yellow carton that holds a 20 mL spray bottle. The affected lots have the lot number 224268 and an expiration date of December 2027. The FDA also listed the product’s NDC number (62795-4005-9) and UPC number (787647 10186 3) for easier identification.

The product was distributed nationwide, both through physical retailers and online sales. That means customers across the country could have purchased the spray, either in stores or from websites.
Why Was the Nasal Spray Recalled?
According to the FDA, the ReBoost Nasal Spray was found to contain yeast, mold, and microbial contamination. One of the microbes identified was a type of bacteria called Achromobacter, detected at levels above acceptable limits.
The FDA warned that there is “a reasonable probability that adverse health consequences, including life-threatening infections, will occur with use of the product in the immunocompromised population.” People with weakened immune systems are at higher risk because their bodies have a harder time fighting infections.
Mold, yeast, and harmful bacteria can cause infections when they are introduced into the body, especially into sensitive areas like the sinuses or lungs. Spraying a contaminated product directly into the nose gives those organisms a direct path into the sinuses and respiratory system.
Possible Symptoms and Health Risks
Health officials say that people using the contaminated nasal spray could experience several symptoms. The Hawaii State Department of Health, which also issued a warning about the product, said possible symptoms may include:
- Fever
- Swollen or painful sinuses
- Headaches
- Face pain or pressure
- Facial numbness

In people with healthy immune systems, an infection might remain mild or moderate. But in people who are immunocompromised, such as some cancer patients, transplant recipients, or people with certain chronic illnesses, these infections can become life-threatening without quick treatment.
So far, as of December 10, MediNatura and the FDA said they had not received any confirmed reports of adverse events related to the recalled spray. However, the recall was issued out of caution because of the potential risks.
What To Do If You Have This Nasal Spray
If you have a bottle of ReBoost Nasal Spray at home, the FDA’s advice is simple: stop using it immediately. Check the packaging for the lot number 224268 and expiration date of December 2027. If it matches, the product is part of the recall.
Health officials recommend taking these steps:
- Do not use the spray again. Discontinue use right away, even if you have not noticed any symptoms yet.
- Contact your doctor if you have used the product and feel unwell, especially if you notice fever, sinus pain, headaches, or facial pressure.
- Follow recall instructions for a refund or return.
Customers who bought the spray directly from MediNatura can request a refund by emailing recall@medinatura.com. If you purchased the product from a store or third-party website, the FDA advises returning it to the place of purchase when possible.
How To Stay Safe With Over-The-Counter Products
Recalls like this can be worrying, especially when they involve products meant to help people feel better during cold and flu season. Here are a few simple habits that can help you stay safe when using over-the-counter health products:
- Check recall notices regularly. The FDA website and state health departments often share alerts about recalled medicines and supplements.
- Inspect packaging. Before using a product, check that the seal is intact and the liquid looks and smells normal. If anything seems off, do not use it.
- Talk to a pharmacist. If you are unsure about a product, ask a pharmacist for guidance or safer alternatives.
- Be extra cautious if you are immunocompromised. People with weakened immune systems should check with their doctors before trying new supplements or homeopathic products.
Company and Regulator Response
MediNatura New Mexico Inc., based in Albuquerque, initiated the voluntary recall in cooperation with the FDA. At the time of the announcement, the company said it had not yet received reports of illnesses tied to the product.
The FDA and state health agencies will likely continue to monitor for any reported adverse events and may update their guidance if new information appears. In the meantime, customers are urged to follow the recall instructions and seek medical care if they feel sick after using the spray.
If you think you may have been affected by this recall or you have questions about your symptoms, your healthcare provider is the best person to help you decide what to do next.
Information in this article is based on public recall notices from the U.S. Food and Drug Administration and state health departments.
To contact us click Here .







